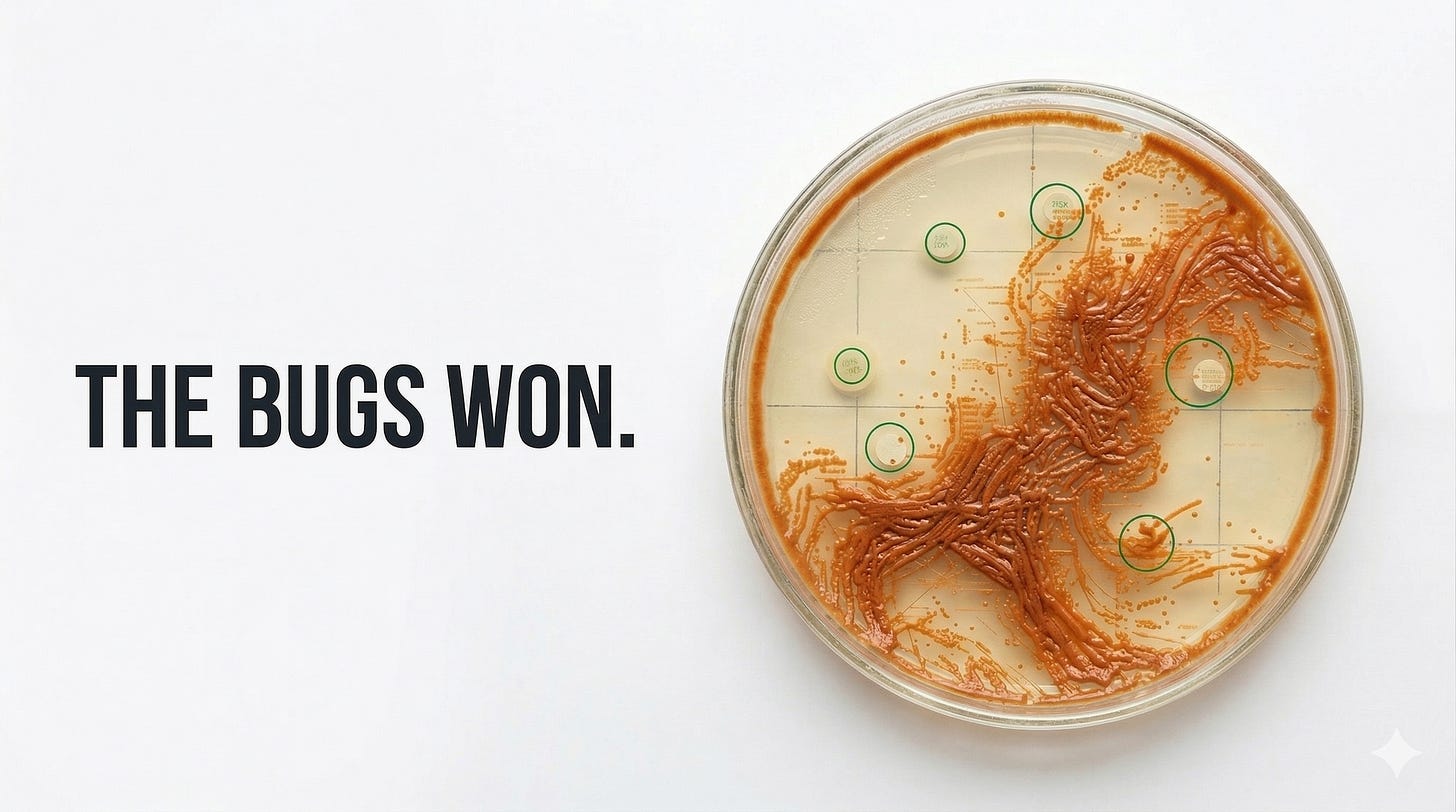

A few weekends ago, I started building this real-time simulator of bacterial evolution and antibiotic resistance (calling it evodish).
I just got around to finishing it up.
Antibiotic resistance is still a very big problem. In the United States alone, more than 2.8 million antimicrobial-resistant infections occur each year.
In this simulator, you drop antibiotic discs into a digital petri dish, natural selection unfolds.
I tried to capture as much biology as possible without overcomplicating it (random mutations, horizontal gene transfer, metabolic fitness costs, etc.).
> 💻 Try it here: evodish.vercel.app
> 📺 Video Guide: